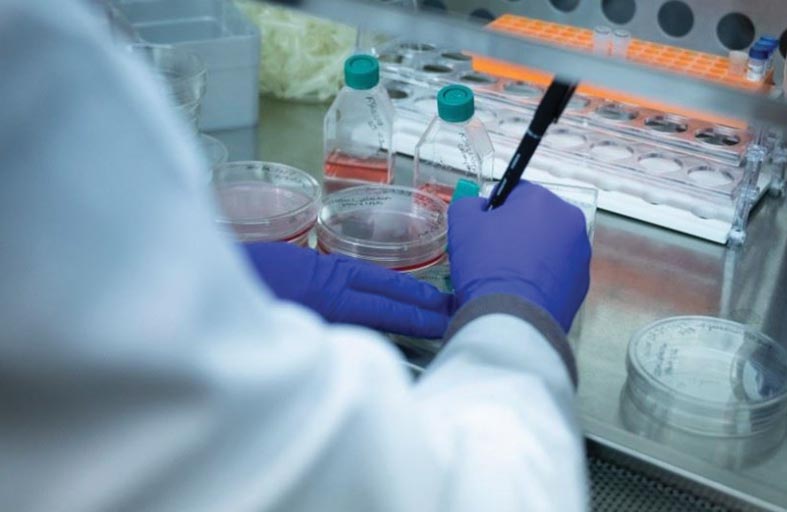

محمد بن راشد يصدر مرسوما بتشكيل مجلس إدارة مؤسسة دبي العقارية برئاسة مكتوم بن محمد
العلاج الجيني يغير حياة مرضى عانوا فقر الدم المنجلي
يروي أميركيان كانا يعانيان من فقر الدم المنجلي لوكالة فرانس برس رحلة كفاحهما ضد هذا المرض، بعد الاستفادة من علاجات مبتكرة، وإن كانت صعبة ومكلفة للغاية، أنهت سنوات طويلة من الألم.
ويأمل المريضان السابقان في رفع مستوى الوعي بهذه العلاجات الجينية، التي حظيت أخيراً بترخيص من السلطات الصحية الأميركية، حتى يتمكن الآخرون من استخدامها.
لكن تكلفتها الباهظة - التي تصل إلى 3,1 ملايين دولار للشخص الواحد - يمكن أن تحد من إمكانية الوصول إليها.
وُلدت تيشا صامويلز في عام 1982، قبيل بدء فحوصات حديثي الولادة لفقر الدم المنجلي، وهو مرض وراثي يصيب حوالي 100 ألف شخص في الولايات المتحدة و20 مليون شخص في جميع أنحاء العالم.
وهو يؤثر بشكل رئيسي على السود. ويقول العلماء إن أحد الأسباب في ذلك هو أن سمة الخلية المنجلية تحمي من الملاريا.
المرضى الذين يعانون من مرض فقر الدم المنجلي لديهم طفرة تؤثر على الهيموغلوبين - وهو بروتين يحمل الأكسجين في خلايا الدم الحمراء. تأخذ خلايا الدم الحمراء بعد ذلك شكلاً منجلياً، ما يحد من تدفق الدم وتوصيل الأكسجين.
العواقب المحتملة مأسوية، وتشمل فقر الدم، ونوبات الألم، وتلف الأعضاء، وصولاً إلى الوفاة المبكرة.
وقد شُخصت حالة تيشا صامويلز في سن الثانية. وفي السابعة من عمرها، عانت من نوبة خطيرة من فقر الدم، وفي الثالثة عشرة من عمرها، أجبرتها سكتة دماغية على الخضوع لعمليات نقل دم شهرية.